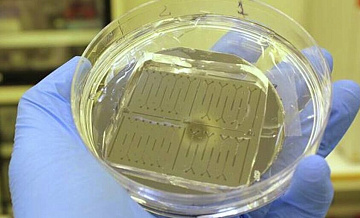
В Петербурге создали прибор для диагностики рака и быстрого старения

Онлайн издание MOS.NEWS - актуальные новости Москвы. Здесь можно получить достоверную и объективную информацию о том, что ежедневно происходит в столице. Наш ресурс для тех, кому интересно все, что касается любимого города. Основной принцип ресурса – правдивое и оперативное освещение событий, соблюдение стандартов качественной журналистики и приоритет интересов москвичей. Наши читатели могут выразить свою точку зрения в комментариях к новостям, обсудить знаковые события в авторских колонках, спланировать отдых с афишей Москвы, принять участие в формировании новостного контента, наконец, узнавать новое и развиваться.